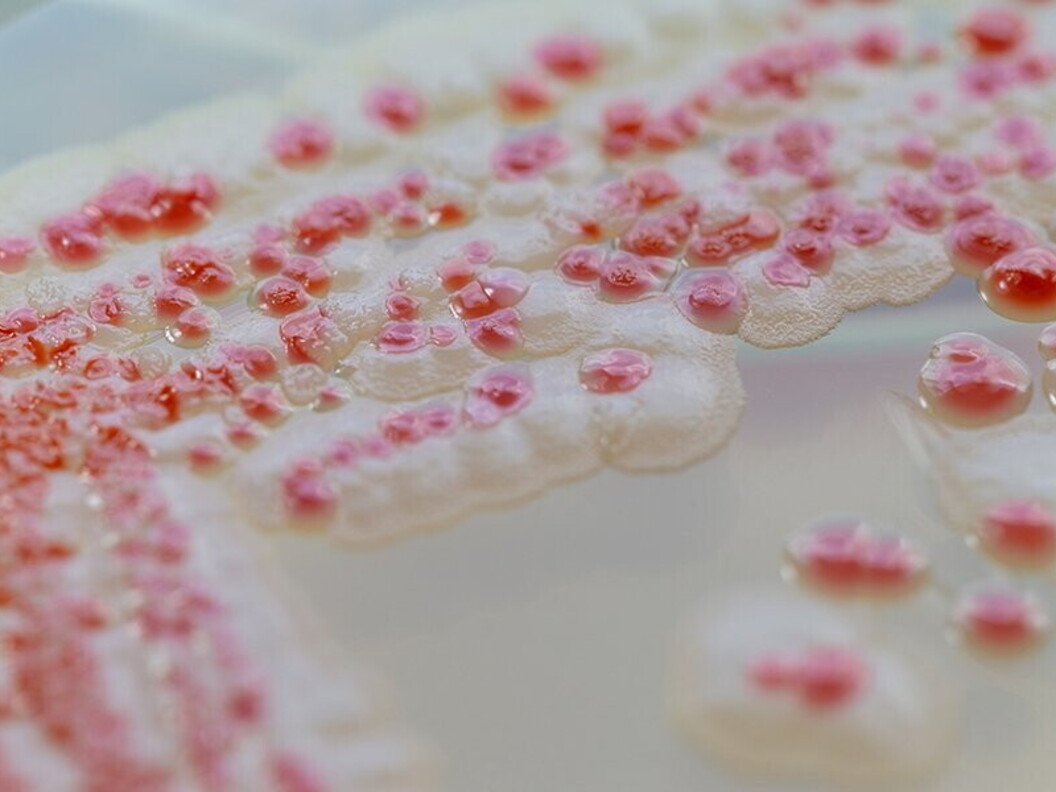
Coltura batterica

Humus
I batteri sono tra i principali organismi decompositori: degradano le sostanze organiche fino a liberare nell’ambiente molecole semplici utilizzabili dagli altri esseri viventi. Il loro ruolo è fondamentale: senza i batteri decompositori le sostanze che permettono la vita non sarebbero più reperibili nell’ambiente. Alcuni batteri, i nitrificanti, demoliscono le proteine liberando composti ricchi di azoto, altri liberano fosforo, zolfo e altre utili sostanze.